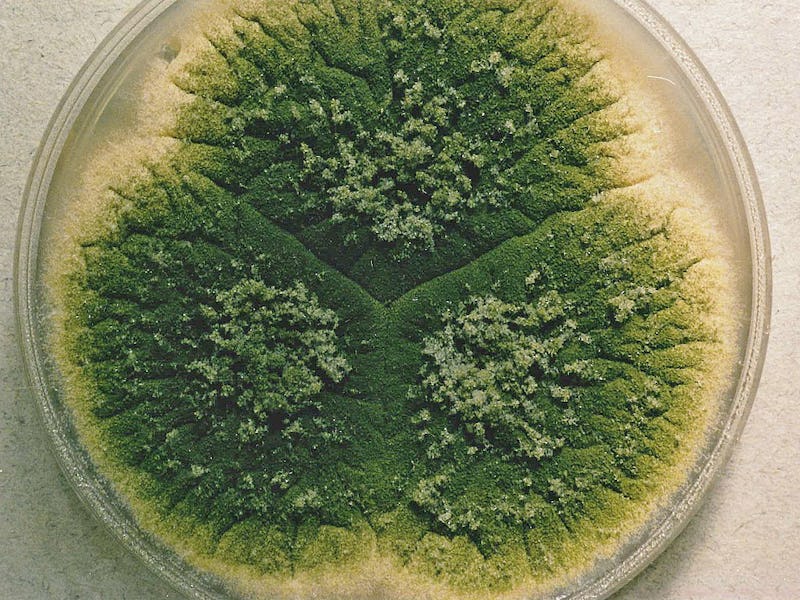

Some People Are Genetically Equipped to Grow Fungus in Their Lungs
This fungus is "unavoidable and inescapable."
In the eighteenth century, an Italian priest who moonlighted as a hobby botanist discovered a family of fungi that can thrive in almost any environment. Today, Aspergillus is known to live in soil, lurk in pillows, sometimes spew from air conditioners, and, according to a new paper in Nature Communications, this “universal and inescapable” fungus also thrives in the lungs of people unlucky enough to carry a certain genetic mutation.
When Pier Antonio Micheli discovered Aspergillus in the 1700s he was struck by how the tiny mold-causing fungus resembled an aspergillum — the instrument used to sprinkle holy water. But the effects of having your lungs blessed by nature’s aspergillus are considerably less heavenly, according to the University of Manchester biological sciences research associate Sarah Gago, Ph.D., the first author on the new paper. In the study, she and her team proposes a new, genetics-based method for screening patients at risk for aspergillosis.
“Aspergillosis is a growing health concern,” Gago tells Inverse. “More than 10 million people worldwide suffer from aspergillosis including invasive, chronic and allergic clinical forms. Mortality due to any clinical form of aspergillosis is higher than 300,000 people a year which is similar to deaths due to global warming.”
Most of the time, breathing in aspergillus doesn’t cause illness. But some forms of chronic aspergillus infections can cause a “fungal ball” in the lungs called an aspergilloma. Here’s how LIFE (Leading International Fungal Education) describes it: “The aspergilloma is a cheesy, friable brown, tan, green, yellow or black material. The fungal ball consists of a dense conglomerate of hyphae arranged in concentric circles.” These tangled balls of mold spores, proteins, and mucus are gross but rare, and in many cases they are asymptomatic.
But the most serious form of infection — invasive aspergillosis — does not feature a fungal ball. What follows is much worse: The fungus travels from the lungs to the bloodstream, where it can spread and lead to organ failure. Gago’s study showed that about four percent of people have a mutation in a gene called ZNF77 that causes it to malfunction — turning their lungs into the perfect breeding grounds for the fungi.
ZNF77 affects the way that cells in the bronchial epithelium — the cells that line a major airway in the lung — interact to fight off infection, says Gago. Normally, cells are attached to one another with with adhesive components that allow them to make up one giant cell layer. Sticking together helps cells communicate to deploy defense measures if an infection threatens them. But if ZNF77 isn’t functioning properly, there are fewer of those cell-to-cell connections, and fungal spores are able to grow freely.
It gets even nastier: ZNF77 malfunction can also help the fungus adhere to the extracellular matrix (the space between and around cells) by overproducing proteins, says Gago. This excess of proteins acts like glue, cementing the fungal spores to the host.
An aspergillum, used to sprinkle holy water, and the fungal ball causing fungus, aspergillus
In her experiments, Gago found that cells with impaired ZNF77 function had 35 percent more fungal spore adhesion in the extracellular matrix, and 10.4 percent more on the lung cells themselves compared to controls with normal ZNF77 function. That’s roughly 17 times more fungus than you would expect from someone who didn’t have this malfunctioning gene.
Gago’s new focus is to see how having this mutation might affect other respiratory infections, like bronchitis. “We are looking at new patient cohorts such as those with bronchitis and invasive disease,” she adds. If her new trials are successful, genetic tests for ZNF77 might be the next form of health screening added the clinical repertoire — just in time for flu season.